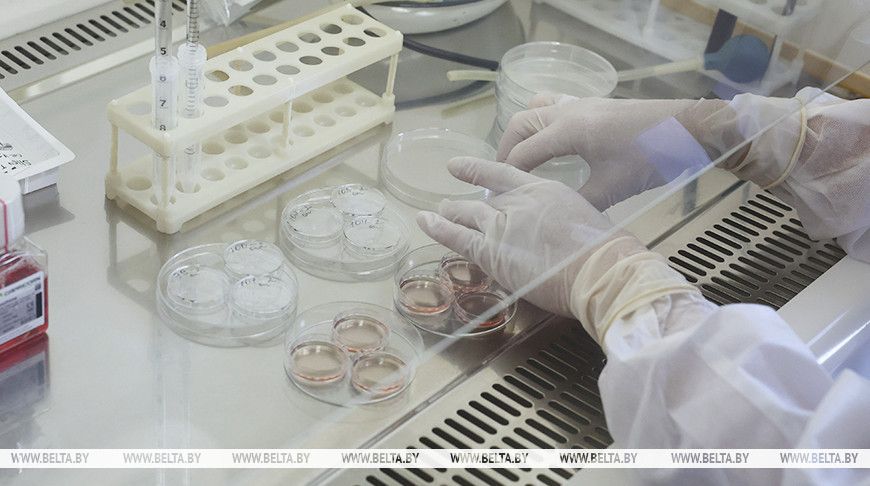
Вторую бесплатную попытку ЭКО могут начать предоставлять в Беларуси с 2026 года

Практически перед каждым человеком, заботящимся о своем здоровье и здоровье своих родных и близких, встает вопрос: «Нужно ли делать прививку от гриппа?». На этот вопрос, а также на ряд других, не менее важных, отвечают специалисты.

– Вирусы гриппа относятся к таким возбудителям, которые имеют чрезвычайно высокую способность изменяться. Поэтому наша иммунная система, встретившись с измененным вирусом гриппа, начинает воспринимать его как новый, ранее не известный вирус. И пока иммунная система «налаживает» производство защитных антител, чтобы бороться с вирусом гриппа, у человека развивается заболевание, – рассказала заведующая поликлиникой Вилейской ЦРБ Светлана Ольтэ.
Именно с изменчивостью вирусов гриппа связаны ежегодные сезонные подъемы заболеваемости. Все нижеуказанные наименования вакцин зарегистрированы Министерством здравоохранения Республики Беларусь и имеют опыт применения в нашей стране и за рубежом. Инактивированные вакцины представлены: Гриппол Плюс (Россия); Инфлювак (Нидерланды); Ваксигрипп (Франция).
Как «работает» вакцина?
– Через 14–21 день после вакцинации развивается иммунитет, который обеспечивает защиту от заболевания гриппом в течение 8–12 месяцев, – отвечает Светлана Валентиновна.
Привился – значит, не заболеешь?
– 100%-ную гарантию от заболевания не дает ни один лечебный, ни один профилактический препарат, – говорит специалист. – В среднем из 100 привитых 98 человек не заболеют гриппом. Если все же привитой человек заболеет гриппом, то заболевание у него будет протекать в легкой форме и без осложнений. Таким образом, вакцинация гарантирует защиту от заболевания тяжелыми и осложненными формами гриппа, заканчивающимися смертельным исходом.
Кто-то не прививается, боясь реакции – температуры, болезненности…
Что является вариантом нормы?
– Возникновение температуры или покраснения в месте введения вакцины – это закономерная реакция на любую вакцину, свидетельствующая о начале формирования защиты к вирусу, – объясняет Светлана Ольтэ. – После вакцинации против гриппа у привитых могут отмечаться следующие реакции. Общие – это реакции, которые в целом затрагивают организм и проявляются в виде повышения температуры тела, недомогания, головной боли и др. Местные – это реакции, которые проявляются в месте введения вакцины в виде уплотнения и болезненности. Все эти проявления кратковременны, не требуют лечения и исчезают самостоятельно в течение 2-3 дней, не нарушая трудоспособности и не требуя дополнительного лечения.
Как отметила главный государственный санитарный врач Вилейского района Наталья Жолнерович, в связи с сезонным подъёмом заболеваемости, пик которой чаще всего приходится на январь – февраль и период, необходимый на выработку иммунитета (3-4 недели), прививку целесообразно выполнить с сентября по ноябрь.
Не стоит надеяться на то, что защитные силы организма сами справятся с инфекцией. Переболеть человек может очень тяжело. Личная иммунная система на большое количество вируса может выработать слишком бурную реакцию. А это способно привести как к осложнениям от вируса гриппа, так и к повреждению собственных тканей. Поэтому всем хроническим пациентам, чтобы их организм во время встречи с настоящим вирусом гриппа выстоял, настоятельно рекомендуется вакцинироваться заранее. Кроме этого, в первую очередь необходимо привиться людям старше 65 лет, работникам образования, медицины, торговли, транспорта.
– Вакцину готовят из убитого, очищенного и разделенного на частички вируса. В маленьком количестве они поступают в наш организм, – уточняет Наталья Александровна, – однако этого достаточно для выработки иммунитета от гриппа.
В лечебных учреждениях района доступны несколько препаратов против гриппа – российская вакцина «Гриппол Плюс» (бесплатно), французская «Ваксигрип Тетра» (платно).
Татьяна ШЕРШНЁВА